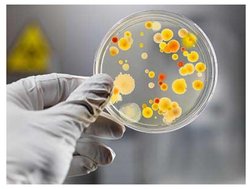

OS CINCO REINOS
Reino Monera ou Procariotos, composto por bactrias e todos os organismos procariontes unicelulares, como as algas azuis.
Reino Protista, composto por todos os organismos eucariontes unicelulares. Reino dos Fungos ou Fungi.:organismos geralmente macroscpios, eucariontes, hetertrofos. Os representantes mais conhecidos so o bolor de po, mofo, orelha de pau, leveduras e o cogumelo
Reino Vegetal ou Plantas (Plantae), organismos imveis que usam a energia solar para realizar a fotossntese e assim obter energia a partir de molculas inorgnicas. Possuem parede celular rgida de celulose. Reino Animal (Animalia), organismos complexos e mveis, eucariontes e heterotrficos. Este reino inclui: esponjas, equinodermos, vermes, moluscos, insetos, peixes, mamferos, aves, rpteis, anfbios e crustceos.
�Bactrias
O reino monera formado por bactrias, cianobactrias (realizam fotossntese), todos seres muito simples, unicelulares e com clula procaritica (sem ncleo diferenciado). As bactrias so encontrados em todos os ecossistemas da Terra e so de grande importncia para a sade, para o ambiente e a economia. As bactrias so encontradas em qualquer tipo de meio: mar, gua doce, solo, ar e, inclusive, no interior de muitos seres vivos. Ao contrrio dos vrus, as bactrias so sensveis a antibiticos. Tambm existem vacinas e soros.
����Exemplos da importncia das bactrias
Na decomposio de matria orgnica morta. Esse processo efetuado tanto aerbia, quanto anaerobiamente;
Agentes que provocam doena no homem; Em processos industriais, como por exemplo, os lactobacilos, utilizados na indstria de transformao do leite em coalhada;
No ciclo do nitrognio, em que atuam em diversas fases, fazendo com que o nitrognio atmosfrico possa ser utilizado pelas plantas; Em Engenharia Gentica e Biotecnologia para a sntese de vrias substncias, entre elas a insulina e o hormnio de crescimento.
�Doenas causadas por bactria
Ttano (ferimentos na pele) Coqueluche (respiratria) Tuberculose (perdigotos) Hansenase (respiratria) Sfilis (DST) Leptospirose (gua e alimentos contaminados com urina de ratos ).
�Reino Protista
A complexidade da clula eucaritica de um protozorio to grande, que ela - sozinha executa todas as funes que tecidos, rgos e sistemas realizam em um ser pluricelular complexo. Locomoo, respirao, excreo, controle hdrico, reproduo e relacionamento com o ambiente, tudo executado por uma nica clula, que conta com algumas estruturas capazes de realizar alguns desses papis especficos, como em um organismo pluricelular.
�Principais espcies de protozorios: -Rizpodes: A movimentao ocorre atravs de pseudpodes e muitas espcies causam doenas nos seres humanos. - Flagelados A movimentao ocorre atravs de flagelos. Tambm so capazes de provocar doenas nos seres humanos.. - Esporozorios So invertebrados unicelulares que vivem como parasitas. - Ciliados O movimento destes animais realizado atravs dos clios..
�Ciliados
Flagelados
Rizpodes
���Trypanosoma cruzi
�Doenas causadas por protozorios Amebase: causada pelo protozorio Entamoeba histolytica. Ela entra no organismo humano por meio de alimentos ingeridos que foram mal lavados e continham os cistos (forma que o protozorio adota quando est fora de um organismo). Doena de Chagas: transmitida pelo barbeiro, um inseto encontrado em vrias partes do Brasil. O protozorio Trypanosoma cruzi passa para o corpo humano quando o barbeiro pica o organismo em busca de sangue. Aps a suco, o barbeiro libera suas fezes na pele, causando coceira. Ao coar, o indivduo acaba por jogar as fezes infectadas do barbeiro em sua corrente sangunea.
�Malria Uma doena histrica, transmitida pelo mosquito Anopheles que possui em seu organismo protozorios do gnero Plasmodium. Os sintomas dessa doena so febre alta, dor de cabea, cansao, entre outros. Toxoplasmose Transmitida por animais domsticos que possuem em seu organismo o protozorio Toxoplasma gondii. uma doena que pode ser assintomtica ou causar dores de cabea, febre, aparecimento de nguas (gnglios linfticos inchados), etc. Tricomonase Causada pelo protozorio Trichomonas vaginalis, a tricomonase transmitida principalmente pelo contato sexual, mas pode ser passada tambm por roupas, toalhas e assentos sanitrios contaminados.
�Fungos
Estrutura Os fungos so compostos por hifas, que so filamentos de clulas que formam uma rede, chamada de miclio. Este, se extende at o alimento, e realiza a absoro de seus nutrientes .
�Alimentao
Os fungos no possuem clorofila, como nas plantas, por isso no podem realizar fotossntese, e consequentemente, no produzem seu prprio alimento. Eles soltam ao seu redor uma substncia chamada exoenzima, que praticamente igual uma enzima digestiva. Essas enzimas digerem molculas organicas do ambiente, e ento o fungo absorve o seu alimento que foi digerido pelas exoenzimas.
������VRUS
Os vrus so seres muito simples e pequenos, formados basicamente por uma cpsula proteica envolvendo o material gentico, que, dependendo do tipo de vrus, pode ser o DNA, RNA ou os dois juntos. A palavra vrus vem do Latim vrus que significa fludo venenoso ou toxina. A palavra vrion ou vron usada para se referir a uma nica partcula viral que estiver fora da clula hospedeira.
���Vrus, seres vivos ou no?
Vrus no tm qualquer atividade metablica quando fora da clula hospedeira: eles no podem captar nutrientes, utilizar energia ou realizar qualquer atividade. Eles se reproduzem, mas diferentemente de clulas, que crescem, duplicam seu contedo, os vrus replicam-se atravs de uma estratgia completamente diferente: eles invadem clulas, ento interagem com o aparato metablico da clula hospedeira, subvertendo o metabolismo celular para a produo de mais vrus.
�Preveno e tratamento
Devido ao uso da maquinaria das clulas do hospedeiro, os vrus tornam-se difceis de matar. As mais eficientes solues mdicas para as doenas virais so, at agora, as vacinas para prevenir as infeces, e drogas que tratam os sintomas das infeces virais. Os pacientes frequentemente pedem antibiticos, que so inteis contra os vrus, e seu abuso contra infeces virais uma das causas de resistncia antibitica em bactrias.
�Principais viroses e formas de contaminao
Resfriado Comum (perdigotos) Caxumba ( respiratria) Raiva ( mordida de animais domticos) Rubola (respiratria) Sarampo (respiratria) Hepatites (A- gua e alimentos, B-sangue e relaes sexuais) Dengue (mosquito Aedes aegypti) Poliomielite (alimentos contaminados ou saliva do doenta) Febre amarela (Aedes aegypti) Varicela ou Catapora (respiratria) Meningite viral (respiratria) Herpes (contato direto com o portador) Condiloma (relaes sexuais) AIDS (relaes sexuais, sangue, leite materno...)
��Existem, por exemplo, soros anti-rbicos (usados contra a raiva), soros antitetnicos (combatem o ttano, doena causada por um tipo de bactria) e soros antiofdicos (combatem o veneno de cobras), entre outros.
�Processo de produo da vacina
O processo de criar, testar e produzir uma vacina em massa pode levar muitos anos porque um processo altamente complexo. Antes mesmo de os cientistas comearem a formular a vacina, os pesquisadores tm que estudar o vrus ou bactria em particular. Basicamente, eles tm que isolar o vrus em um ambiente de laboratrio e descobrir como ele provoca a doena. Eles, ento, desenvolvem a vacina como atenuada ou inativada, dependendo do tipo de vrus ou de bactria.
�FIM
[Link]